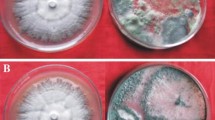

Abstract
The induced immunity in long cayenne pepper in terms of phytoalexin production using microbial elicitors as chaetoglobosin C from Chaetomium globosum, chaetomanone A from Chaetomium lucknowense, and trichotoxin A50 from Trichoderma harzianum PC01 was investigated in pot experiments. Stem inoculation of chilli plants with Colletotrichum capsici isolate C208 resulted in necrosis and accumulation of capsidiol, a phytoalexin. Stem inoculation of chilli plants resulted in different degrees of sensitivity to C. capsici, expressed as necrosis along the stems. The microbial elicitors chaetoglobosin C, chaetomanone A, and trichotoxin A50 induced an immunity response against C. capsici. Qualitative analysis of capsidiol accumulation in the upper part of the chilli plant was detected by thin-layer chromatography and showed that capsidiol had accumulated in the chilli plant at 5 and 10 days after treatment with the microbial elicitors, whereas no capsidiol was detected in the noninoculated and untreated plants. Chilli cultivation of long cayenne pepper in vivo was conducted by spraying chaetoglobosin C, chaetomanone A, and trichotoxin A50, and the findings were compared with cultivation using a chemical fungicide (difenoconazole). The results showed that application of each microbial elicitor reduced disease incidence by 42–55 % when compared with an inoculated control, whereas difenoconazole reduced disease incidence by 33 %. Additionally, the yield increased by 47–55 % when compared with the yield for the inoculated control. Chilli cultivation of long cayenne pepper in vivo using the biological fungicides Bio-CG from C. globosum N0802, Bio-CLT from C. lucknowense CLT, and Bio-T from T. harzianum PC01 resulted in reduction of disease incidence by 39–55 % when compared with the inoculated control, whereas difenoconazole reduced disease incidence by 33 %. Moreover, treatment with Bio-CG, Bio-CLT, and Bio-T increased the yield by 39–53 % when compared with yield for the inoculated control.
Moreover, the bioactive compounds chaetoglobosin C, chaetomanone A, and trichotoxin A50 were used as microbial elicitors to elicit α-tomatine in tomato. α-Tomatine was detected by high-performance liquid chromatography after treatment with the bioactive compounds. Chaetoglobosin C, chaetomanone A, and trichotoxin A50 were sprayed onto inoculated tomato seedling variety Sida inoculated with Fusarium oxysporum f. sp. lycopersici NKSC01, and plant disease immunity and quantity of α-tomatine were assessed. The results revealed that plant disease immunity of tomato seedlings treated with chaetoglobosin C, chaetomanone A, and trichotoxin A50 at a concentration of 50 μg/ml after 10 days was 44.97, 35.18, and 39.43 %, respectively, whereas tomato seedlings treated with prochloraz that showed plant disease immunity of 29.95 %. The stems and leaves of tomato were extracted and spotted on thin-layer chromatography paper and produced a green spot with a retention factor of 0.23, the same as for a spot of standard α-tomatine. Tomato extracts were analyzed for α-tomatine by high-performance liquid chromatography. The α-tomatine quantification data were analyzed using a linear regression curve. Tomato treated with chaetoglobosin C, chaetomanone A, and trichotoxin A50 at 15 days expressed α-tomatine at levels of 207.87, 254.25, and 205.04 μg/g, levels which are significantly higher than those resulting from prochloraz and inoculation treatments, for which the quantities of α-tomatine were 131.56 and 77.46 μg/g, respectively. It is shown that the induction of α-tomatine by chaetoglobosin C, chaetomanone A, and trichotoxin A50 in tomato plants implies disease immunity against fusarium wilt of tomato variety Sida through phytoalexin production. The bioactive compounds were tested for their efficacies to control tomato wilt in vivo. The results revealed that all the bioactive compounds at concentrations of 10, 50, and 100 μg/ml could induce plant disease immunity in tomato between 53.80 and 65.15 %, which is significantly higher than the plant disease immunity induced by prochloraz, which was 26.73 %.
Access provided by Autonomous University of Puebla. Download chapter PDF
Similar content being viewed by others
Keywords
1 Microbial Elicitors Inducing Plant Disease Immunity in Chilli
The prospect of broad-spectrum disease control using the plant’s own resistance mechanisms has increased interest in the development of agents which can mimic natural inducers of resistance (Walters et al. 2005). Research on resistance mechanisms has shown that plant defenses are activated after infection. Many biochemical changes occur in plants after infection, and some of these have been associated with the expression of defense because they have activities against pathogens in vitro (Hammerschmidt 1999). One type of biochemical response that is strongly associated with defense is the accumulation of phytoalexins, which are low molecular weight antimicrobial compounds that are produced after infection. Their production is triggered either by pathogen attack or by biotic and abiotic elicitors such as synthetic chemicals, substances from microorganisms, polysaccharides, proteins, and cellulose (Chávez-Moctezuma and Lozoya-Gloria 1996; Walters et al. 2005). Phytoalexins are produced by plants not only in response to interactions with fungi or other living organisms, but also following treatment with many chemicals, irradiation by ultraviolet light, and exposure to the products of microbial metabolites (Zbell and Walter-Back 1989). In addition, phytoalexin production can also be induced by fungicides. Hwang and Sung (1989) demonstrated that metalaxyl induced the phytoalexin capsidiol in the stem of chilli plants infected with Phytophthora capsici.
Capsidiol is the major phytoalexin that accumulates in tobacco (Nicotiana tabacum) and chilli (Capsicum annuum) in response to fungal infection as reported by Hoshino et al. (1995). Capsidiol is biosynthetically derived from the mevalonate pathway via farnesyl pyrophosphate. Farnesyl pyrophosphate is a key intermediate in the biosynthesis of terpenes. Specific cyclization reactions of farnesyl pyrophosphate are catalyzed by particular sesquiterpene cyclases. The enzyme 5-epi-aristolochene synthase from tobacco and chilli produces 5-epi-aristolochene, which is the immediate precursor of the bicyclic phytoalexin capsidiol (Zook et al. 1996; Back et al. 1998; Zavala-Páramo et al. 2000). The sesquiterpenoid phytoalexin capsidiol, the principal phytoalexin of C. annuum, has been isolated from fruits, leaves, and stems of chilli. Watson and Brooks (1984) reported pectinase (from Aspergillus niger) and cellulase (from Trichoderma viride) caused rapid accumulation of capsidiol in the diffusates and flesh of green chillies, and apparently that was the first reported example of the potency of these two agents in eliciting sesquiterpenoid phytoalexins. Capsidiol production was observed in vitro root cultures of chilli after treatment with cellulase. The maximal secretion of capsidiol to the medium was achieved at 24 h after treatment (Chávez-Moctezuma and Lozoya-Gloria 1996). Ma (2008) reported that the production of a sesquiterpenoid from a C. annuum suspension culture was induced by the elicitor cellulase, and the induced compound, capsidiol, mainly accumulated in the culture medium. Moreover, the elicitation may be mediated by a second messenger, jasmonic acid, linked by preceding phospholipase A2 activation. Bhandal and Paxton (1991) suggested that Polytran L, a commercially produced glucan of fungal origin, can be used as an elicitor at 0.25 % (w/v) for inducing capsidiol accumulation in unripe chilli fruits. The resistance of C. annuum to chilli blight causd by P. capsici was observed after inoculating the chilli stems with the fungal pathogen. Capsidiol accumulated in the area of necrosis and appeared to be involved in this resistance (Egea et al. 1996a, b; García-Pérez et al. 1998). Ahmed et al. (2000) suggested that Trichoderma harzianum probably uses a combination of biocontrol mechanisms against P. capsici to induce resistance in chilli.
As microbial elicitors, we evaluated pure compounds from fungi—namely, chaetoglobosin C from Chaetomium globosum, chaetomanone A from Chaetomium lucknowense, and trichotoxin A50 from T. harzianum (Fig. 6.1). Stock solutions (50 ml) of each microbial elicitor at a concentration of 1,000 μg/ml were prepared by dissolving 0.05 g of the elicitor in dimethyl sulfoxide. Then, the stock solutions were diluted with distilled water to elicitor concentrations of 10, 50, and 100 μg/ml.
The immunity induced in long cayenne pepper plants as shown by phytoalexin production was achieved by inoculation with a highly virulent Colletotrichum isolate, using the plug inoculation method over the wounded stem (5 mm long). Five-millimeter-diameter plugs of the Colletotrichum isolate were cut from the edge of the colony, the wounded sites were inoculated with the Colletotrichum isolate, and were then covered with aluminum foil containing moist cotton wool (Fig. 6.2a). Noninoculated chilli plants were also wounded on their stems, and only a potato dextrose agar plug was placed over the wound; they were not inoculated with the pathogen and were not treated with the microbial elicitors. Then, chilli plants were separately treated by spraying the microbial elicitors—chaetoglobosin C, chaetomanone A, and trichotoxin A50—over the plant canopy. The experiments were performed as three factor factorial (2 × 3 × 4) experiments in a randomized complete block design with three replications. Factor A was the inoculation conditions, where A1 represented no inoculation and A2 represented inoculation, factor B was the microbial elicitors, where B1 represented chaetoglobosin C, B2 represented chaetomanone A, and B3 represented trichotoxin A50, and factor C was the concentrations, where C1 represented 0 μg/ml, C2 represented 10 μg/ml, C3 represented 50 μg/ml, and C4 represented 100 μg/ml.
The length of the necrosis lesion on the stems was measured at 5, 10, and 20 days after treatment, and the accumulation of capsidiol was also measuered at 5, 10, and 20 days after treatment. To detect capsidiol, the upper parts of the chilli plant (Fig. 6.2b) were cut off and ground to a fine powder with a mortar and pestle using liquid nitrogen. Capsidiol was extracted from the resulting powder by adding a mixture of dichloromethane and methanol (2:1, v/v) following a modified protocol of Egea et al. (1996a). Plant debris was removed by filtration, and then the extract was washed with water and with dichloromethane. Finally, the organic phase was evaporated to dryness, redissolved in dichloromethane, and subjected to thin-layer chromatography (TLC) and developed with a mixture of hexane and ethyl acetate (1:1, v/v). The capsidiol spot was detected after spraying the TLC plate with vanillin reagent (1 g of vanillin in 30 ml of methanol, to which 0.2 ml of concentrated sulfuric acid was added). A characteristic blue spot with a retention factor (Rf) of 0.2 developed after the TLC plate had been heated at 80 °C by 3–4 min.
Long cayenne pepper seedlings were transplanted into 11-in.-diameter plastic pots which contained sterilized soil mixture (soil–sand–compost, 4:1:1). Thirty-day-old chilli plants, except for the noninoculated control, were inoculated by spraying the spore suspension (1 × 106 conidia per milliliter) over the plant canopy (2 ml per plant). The experiment was performed by using a randomized complete block design with four replications (five plants per replication). The treatments were designed as follows: T1 represented the untreated control, T2 represented the inoculated control, T3 represented treatment with chaetoglobosin C at a concentration of 50 μg/ml every 15 days, T4 represented treatment with chaetomanone A at a concentration of 50 μg/ml every 15 days, T5 represented treatment with trichotoxin A50 at a concentration of 50 μg/ml every 15 days, and T6 represented treatment with a chemical fungicide (difenoconazole) at the recommended rate (10 ml per 20 l of water) every 15 days. The number of fruits which showed anthracnose symptoms per plant was used as a measure of disease incidence. Disease incidence was assessed at 90 days after treatment and was based on a disease rating scale (modified from Gopinath et al. 2006) as follows:1 for uninfected fruit, 2 for 1–25 % of fruits infected per plant, 3 for 26–50 % of fruits infected per plant, 4 for 51–75 % of fruits infected per plant, and 5 for 76–100 % of fruits infected per plant. The percent disease reduction (PDR) was calculated as follows:
Plant height (cm) was recorded every 15 days. Moreover, plant fresh weight (g), root fresh weight (g), plant dry weight (g), and root dry weight (g) were recorded at harvesting (90 days after treatment). Fruit diameter (cm), fruit length (cm), and fruit weight per plant (g) were also recorded. The percent increase in yield (PIY) was calculated as follows:
Data were analyzed by analysis of variance. Treatment means were statistically compared by Duncan’s multiple range test at P = 0.05 and P = 0.01.
Biological fungicides were separately formulated from C. globosum KMITL-N0802, C. lucknowense CLT, and T. harzianum PC01 as oil formulations according to the work of Soytong et al. (2001)—namely, Bio-CG, Bio-CLT, and Bio-T, and were separately tested for their abilities to induce immunity in chilli against anthracnose. Long cayenne pepper seedlings were transplanted into 11-in.-diameter plastic pots which contained sterilized soil mixture (soil–sand–compost, 4 1 1). Thirty-day-old chilli plants, except for the noninoculated control, were inoculated by spraying the spore suspension (1 × 106 conidia per milliliter) over the plant canopy (2 ml per plant). The experiment was peformed by using a randomized complete block design with four replications (five plants per replication). Treatments were designed as follows:T1 represented the untreated control, T2 represented the inoculated control, T3 represented treatment with Bio-CG at a rate of 10 ml per 20 l of water every 15 days, T4 represented treatment with Bio-CLT at a rate of 10 ml per 20 l of water every 15 days, T5 represented treatment with Bio-T at a rate of 10 ml per 20 l of water every 15 days, and T6 represented the treatment with a chemical fungicide (difenoconazole) at the recommendation rate (10 ml per 20 l of water) every 15 days. The number of fruits which showed anthracnose symptoms per plant was used as a measure of disease incidence. Disease incidence was assessed at 90 days after treatment and was based on a disease rating scale (modified from Gopinath et al. 2006) as follows: 1 for uninfected fruit, 2 for 1–25 % of fruits infected per plant, 3 for 26–50 % of fruits infected per plant, 4 for 51–75 % of fruits infected per plant, and 5 for 76–100 % of fruits infected per plant. The PDR was calculated as follows:
Plant height (cm) was recorded every 15 days. Moreover, plant fresh weight (g), root fresh weight (g), plant dry weight (g), and root dry weight (g) were recorded at harvesting (90 days after treatment). Fruit diameter (cm), fruit length (cm), and fruit weight per plant (g) were also recorded. The PIY was calculated as follows:
Data were analyzed by analysis of variance. Treatment means were statistically compared by Duncan’s multiple range test at P = 0.05 and P = 0.01.
The immunity induced in long cayenne pepper plants as shown by phytoalexin production was assessed by inoculation with the highly virulent C. capsici isolate C208, using the plug inoculation method over the wounded stem and treatment by spraying the microbial elicitors—chaetoglobosin C, chaetomanone A, and trichotoxin A50—thoroughly over the plant canopy. The experiments were performed as three factor factorial (2 × 3 × 4) experiments in a randomized complete block design with three replications. Factor A was the inoculation conditions, where A1 represented no inoculation and A2 represented inoculation, factor B was the microbial elicitors, where B1 represented chaetoglobosin C, B2 represented chaetomanone A, and B3 represented trichotoxin A50, and factor C was the concentrations, where C1 represented 0 μg/ml, C2 represented 10 μg/ml, C3 represented 50 μg/ml, and C4 represented 100 μg/ml. The results showed that stem inoculation of chilli plants with C. capsici isolate C208 resulted in necrosis and accumulation of capsidiol. Stem inoculation of chilli plants showed different degrees of sensitivity to the fungal pathogen C. capsici, expressed as necrosis along the stems. Treatment with all three microbial elicitors induced an immunity response against C. capsici in the upper part of the chilli plant. The length of the necrosis was significantly different at 5 days after treatment with the microbial elicitors. For both no inoculation and inoculation followed by treatment with chaetoglobosin C, chaetomanone A, and trichotoxin A50 at concentrations of 10, 50, and 100 μg/ml, there was no significant difference in the length of the necrosis, but the difference was significant when compared with the lengths of the necrosis of plants inoculated with the pathogen and not treated with chaetoglobosin C, chaetomanone A, and trichotoxin A50, for which the lengths of the necrosis were 8.0, 8.3, and 8.3 mm, respectively. The length of the necrosis on the plants not inoculated with the pathogen and treated with chaetoglobosin C, chaetomanone A, and trichotoxin A50 at concentrations of 10, 50, and 100 μg/ml was the same—5.0 mm. The lengths of the necrosis on the plants inoculated with the pathogen and treated with chaetoglobosin C at concentrations of 10, 50, and 100 μg/ml were 5.3, 5.3, and 5.2 mm, respectively, lengths which are shorter than the length of the necrosis on the plants inoculated with the pathogen and treated with chaetomanone A and trichotoxin A50. The lengths of the necrosis on the plants inoculated with the pathogen and treated with chaetomanone A at concentrations of 10, 50, and 100 μg/ml were 5.3, 5.5, and 5.4 mm, respectively, whereas the lengths of the necrosis on the plants inoculated with the pathogen and treated with trichotoxin A50 at concentrations of 10, 50, and 100 μg/ml were 6.1, 5.8, and 5.9 mm, respectively.
The lengths of the necrosis on the plants not inoculated with the pathogen and treated with chaetoglobosin C, chaetomanone A, and trichotoxin A50 at concentrations of 10, 50, and 100 μg/ml and on the plants inoculated with the pathogen and treated with chaetoglobosin C, chaetomanone A, and trichotoxin A50 at concentrations of 10, 50, and 100 μg/ml were not increased at 10 and 20 days after treatment with the microbial elicitors, whereas at 10 days the lengths of the necrosis on the plants inoculated with the pathogen and not treated with chaetoglobosin C, chaetomanone A, and trichotoxin A50 were 11.0, 11.3, and 11.7 mm, respectively, which are significantly different from those resulting from the other treatments. At 20 days the lengths of the necrosis on the plants inoculated with the pathogen and not treated with chaetoglobosin C, chaetomanone A, and trichotoxin A50 were 14.0, 14.3, and 14.3 mm, respectively, which are significantly different from those resulting from the other treatments (Table 6.1 and Fig. 6.3).
Qualitative analysis of capsidiol accumulation in the upper part of the chilli plant was detected by TLC according to the establishment a blue spot and the respective Rf (0.2). Capsidiol was detected in chilli plants at 5 and 10 days after treatment with chaetoglobosin C, chaetomanone A, and trichotoxin A50 at concentrations of 10, 50, and 100 μg/ml in both no-inoculation and inoculation treatments, whereas capsidiol was not detected in plants that were not inoculated and not treated with chaetoglobosin C, chaetomanone A, and trichotoxin A50. After 20 days, for all the treatments, capsidiol was not detected in the plants (Fig. 6.4).
Moreover, microbial elicitors and a chemical fungicide (difenoconazole) were applied to the pathogen-inoculated chilli plants. Disease incidence after treatment with chaetoglobosin C was 2.00 (18.68 % of fruits infected per plant), which was significantly different when compared with disease incidence after difenoconazole treatment (3.00; 31.06 % of fruits infected per plant) (P = 0.05). Fo treatment with chaetomanone A and trichotoxin A50, disease incidence was 2.25 (24.96 %of fruits infected per plant) and 2.50 (26.36 % of fruits infected per plant), respectively. The plants inoculated with the pathogen exhibited the highest disease incidence, which was 4.50 (74.65 % of fruits infected per plant), whereas te untreated control showed no anthracnose symptoms on chilli fruit. Chaetoglobosin C, chaetomanone A, and trichotoxin A50 induced immunity in chilli against anthracnose which significantly reduced disease incidence by 55.0, 50.0, and 42.5 %, respectively, when compared with difenoconazole, which reduced disease incidence by only 32.5 % (Table 6.2). All microbial elicitors tested resulted in significantly higher plant growth parameters (plant height, root length, plant fresh and dry weight, and root fresh and dry weight) than for the inoculated control at 90 days. The plant height at 15 days after treatment with chaetoglobosin C was 12.88 cm, which was the highest and was significantly different from the heights resulting from the other treatments (P = 0.05),. For treatment with chaetomanone A, the plant height was 11.28 cm. For plants treated with trichotoxin A50 and difenoconazole and the untreated control, the plants heights were not significantly different—8.33, 8.53, and 7.85 cm, respectively. The plant height of the inoculated control was 5.95 cm, which was the lowest height and significantly differed from the heights resulting from the other treatments (Table 6.3). The plant height at 30 days after treatment with chaetoglobosin C was 29.85 cm, which was the highest and significantly differed from the heights resulting from the other treatments (P = 0.05). For plants treated with chaetomanone A and trichotoxin A50 and the untreated control, the plant heights were not significantly different (18.28, 18.23, and 19.63 cm, respectively), in contrast to the plant height resulting from treatment with difenoconazole (15.10 cm). The plant height of the inoculated control was 11.03 cm, which was the lowest plant height and significantly differed from the heights resulting from the other treatments.
Chaetoglobosin C promoted plant growth significantly differently from the other treatments at 45 days after treatment (P = 0.05). For treatment with chaetoglobosin C, the plant height was 36.48 cm, whereas for treatment with chaetomanone A, the plant height was 31.33 cm. For plants treated with trichotoxin A50 and difenoconazole and the untreated control, there was no significant difference in the plant heights, which were 25.40, 25.05, and 25.75 cm, respectively. The plant height of the inoculated control was 21.04 cm, which was the lowest plant height and significantly differed from the heights resulting from the other treatments (Table 6.3, Fig. 6.5). The plant height at 60 days after treatment showed that all the microbial elicitors tested resulted in significantly different plant heights when compared with the chemical fungicide (P = 0.05). Chaetoglobosin C promoted plant growth significantly differently from the other treatments. For treatment with chaetoglobosin C, the plant height was 38.65 cm, and for treatment with chaetomanone A and trichotoxin A50, the plant heights were 34.15 and 32.05 cm, respectively. For the plants treated with difenoconazole and the untreated control, there was no significant difference in the plant heights, which were 27.35 and 26.05 cm, respectively, whereas the plant height of the inoculated control was 23.90 cm, which was the lowest plant height and significantly differed from the heights resulting from the other treatments (Fig. 6.6). It was clearly demonstrated that at 90 days after treatment, treatment with all the microbial elicitors tested also resulted in significantly different plant heights when compared with the chemical fungicide (P = 0.05). Chaetoglobosin C promoted plant growth significantly differently from the other treatments. For treatment with chaetoglobosin C, the plant height was 53.15 cm, whereas for treatment with chaetomanone A and trichotoxin A50, the plant heights were 51.08 and 48.90 cm, respectively. For the plants treated with difenoconazole and the untreated control, there was no significant difference in the plant heights, which were 41.83 and 40.60 cm, respectively, whereas the plant height of the inoculated control was 34.35 cm, which was the lowest plant height and significantly differed from the heights resulting from the other treatments (Fig. 6.7). There was a significant difference in the root length at 90 days after treatment. Treatment with all the microbial elicitors tested resulted in a significant difference in the root length when compared with the chemical fungicide (P = 0.05). Treatment with chaetoglobosin C resulted in a significantly different root length of 40.50 cm, whereas treatment with chaetomanone A and trichotoxin A50 resulted in root lengths of 32.55 and 32.13 cm, respectively. For the plants treated with difenoconazole and the untreated control, there was no significant difference in the root lengths, which were 29.13 and 28.03 cm, respectively, whereas the root length of the inoculated control was 22.53 cm, which was the shortest root length and significantly differed from the root lengths resulting from the other treatments (Fig. 6.8). The plant fresh and dry weights showed that treatment with all the microbial elicitors tested resulted in significantly different plant fresh and dry weights when compared with the chemical fungicide (P = 0.05). Treatment with chaetoglobosin C resulted in a significantly different plant fresh weight, which was 54.81 g, whereas treatment with chaetomanone A and trichotoxin A50 resulted in plant fresh weights of 46.06 and 44.69 g, respectively. For the plants treated with difenoconazole and the untreated control, there was no significant difference in the plant fresh weights, which were 35.67 and 35.16 g, respectively, whereas the plant fresh weight of the inoculated control was 25.79 g, which was the lowest plant fresh weight and significantly differed from the fresh weights resulting from the other treatments. Likewise, the plant dry weight after treatment with chaetoglobosin C was 17.29 g, which significantly differed from the dry weights resulting from the other treatments, For treatment with chaetomanone A and trichotoxin A50, the plant dry weights were 13.96 and 13.23 g, respectively. For the plants treated with difenoconazole and the untreated control, there was no significant difference in the plant dry weights, which were 10.07 and 9.77 g, respectively, whereas the plant dry weight of the inoculated control was 6.82 g, which was the lowest plant dry weight and significantly differed from the dry weights resulting from the other treatments. The root fresh weight showed that for all the microbial elicitors tested, there was a significant difference in the root fresh weight when compared with the root fresh weight of the inoculated control (P = 0.05). The root fresh weight after treatment with chaetoglobosin C was 11.06 g, which was significantly different from the root fresh weight resulting from the other treatments. For plants treated with chaetomanone A, trichotoxin A50, and difenoconazole and the untreated control, the root fresh weights were 9.70, 9.19, 8.60, and 8.41 g, respectively. The root fresh weight of the inoculated control was 7.54 g, which was the lowest root fresh weight and significantly differed from the root fresh weights resulting from microbial elicitor treatments. However, the root dry weight showed that for all the elicitors tested there was a significant difference in the root dry weight when compared with the root dry weight resulting from treatment with the the chemical fungicide (P = 0.05). The root dry weight after treatment with chaetoglobosin C was 2.75 g, which significantly differed from the root dry weight after the other treatments. For treatment with chaetomanone A and trichotoxin A50, the root dry weights were 2.53 and 2.34 g, respectively. For the plants treated with difenoconazole and the untreated control, there was no significant difference in the root dry weights, which were 2.06 and 2.01 g, respectively, whereas the root dry weight of the inoculated control was 1.63 g, which was the lowest root dry weight and significantly differed from the root dry weights resulting from the other treatments (Table 6.4).
In addition to reducing disease incidence, application of microbial elicitors also increased fruit yield and the overall quality of the fruits. For all the microbial elicitors tested, the number of fruits per plant was significantly different when compared with the number of fruits per plant for the inoculated control (P = 0.05). Treatment with Chaetoglobosin C resulted in the highest fruit number, which was 13.10 fruits per plant, followed by treatment with chaetomanone A, trichotoxin A50, and difenoconazole, for which the fruit numbers were 12.40, 12.25, and 10.85 fruits per plant. The lowest fruit numbers were obtained for the untreated control and the inoculated control, and were 10.15 and 8.50 fruits per plant, respectively (Table 6.2 and Fig. 6.9).
For all the microbial elicitors tested, the overall quality of the fruit was significantly different when compared with that resulting from treatment with the chemical fungicide (P = 0.05). The fruit lengths after treatment with chaetoglobosin C and chaetomanone A were 10.78 and 10.36 cm, respectively, which were the longest and significantly differed from the lengths resulting from the other treatments. For treatment with trichotoxin A50, the fruit length was 9.37 cm. For the plants treated with difenoconazole, the untreated control, and the inoculated control, there was no significant difference in the fruit lengths, which were 8.13, 8.38, and 7.68 cm, respectively. The fruit diameter after treatment with the microbial elicitors was significantly different when compared with the fruit diameter after the other treatments. The fruit diameter of chaetoglobosin C was 1.64 cm, which was the largest diameter. For treatment with chaetomanone A and trichotoxin A50, the fruit diameters were 1.57 and 1.50, respectively. The smallest fruit diameters were obtained for the plants treated with difenoconazole, the untreated control, and the inoculated control, and were 1.39, 1.36, and 1.30 cm, respectively (Table 6.2).
Moreover, the results showed that for all the microbial elicitors tested, the yield was significantly different from that resulting from treatment with the chemical fungicide (P = 0.05). Treatment with chaetoglobosin C resulted in the highest yield, which was 124.64 g per plant, followed by treatment with chaetomanone A and trichotoxin A50, which resulted in yields of 113.58 and 106.43 g per plant, respectively. For the plants treated with difenoconazole, the untreated control, and the inoculated control, there was no significant difference in the yields, which were 76.11, 68.57,and 55.89 g per plant, respectively. Lastly, the increases in yield after treatment with chaetoglobosin C, chaetomanone A, and trichotoxin A50 were 55.17, 48.49, and 46.53 %, respectively, which significantly differed from the increase in yield after treatment with difenoconazole (25.31 %).
Biological fungicides formulated in an oil form—namely, Bio-CG, Bio-CLT, and Bio-T—were tested in comparison with a chemical fungicide (difenoconazole) in pot experiments for 90 days. The disease incidence after treatment with Bio-CG was 2.00 (19.41 % of fruits infected per plant), which was significantly different when compared with the disease incidence after treatment with difenoconazole (3.00; 29.16 % of fruits infected per plant) (P = 0.05). For treatment with Bio-CLT and Bio-T, the disease incidences were 2.50 (26.04 % of fruits infected per plant) and 2.75 (27.64 % of fruits infected per plant), respectively. The highest disease incidence of 4.50 (75.28 % of fruits infected plant) occurred with the inoculated control, and significantly differed from the disease incidences resulting from the other treatments, whereas the untreated control showed no anthracnose symptoms on chilli fruit. For treatment with Bio-CG and Bio-CLT, the reduction of disease incidence on chilli fruit was significantly different, for which the PDR was 55.00 and 42.50 %, respectively, when compared with diseases incidence following treatment with difenoconazole (P = 0.05). The PDR of the Bio-T and difenoconazole treatments was 38.75 and 32.50 %, respectively (Table 6.5).
Treatment with all the biological fungicides resulted in significantly higher plant growth parameters (plant height, root length, plant fresh and dry weights, and root fresh and dry weights) than for the inoculated control. The plant height at 15 days after treatment with Bio-CG was 12.13 cm, which was the highest and significantly differed from the plant heights resulting from the other treatments (P = 0.05). For treatment with Bio-CLT, the plant height was 10.93 cm. For the plants treated with Bio-T and difenoconazole and the untreated control, there was no significant difference in the plant heights, which were 8.36, 8.29, and 8.33 cm, respectively. The lowest plant height occurred for the inoculated control (7.03 cm), and was significantly different from the plant heights resulting from the other treatments (Fig. 6.10). Bio-CG also promoted plant growth significantly differently (the plant height was 28.10 cm) when compared with the other treatments for 30 days (P = 0.05). For the plants treated with Bio-CLT, Bio-T, and difenoconazole and the untreated control, the plant heights were 20.19, 18.09, 16.30, and 19.95 cm, respectively (Fig. 6.11). The plant height at 45 days after treatment showed that treatment wit Bio-CG and Bio-CLT resulted in significantly different plant heights, which were 36.15 and 35.05 cm, respectively, when compared with the other treatments (P = 0.05). For the plants treated with Bio-T and difenoconazole and the untreated control, the plant heights were 27.23, 25.80, and 23.85 cm, respectively. The plant height of the inoculated control was 20.78 cm, which was the lowest plant height and significantly differed from the plant heights resulting from the other treatments (Fig. 6.12). The plant height at 60 days after treatment showed that treatment with all the biological fungicides tested resulted in significantly different plant heights when compared with the plant height resulting from treatment with the chemical fungicide (P = 0.05). Bio-CG promoted plant growth significantly differently, and the resulting plant height was 40.45 cm. For treatment with Bio-CLT and Bio-T, the resulting plant heights were 36.05 and 32.80 cm, respectively. For the plants treated with difenoconazole and the untreated control, there was no significant difference in the plant heights, which were 28.35 and 27.85 cm, respectively, whereas the plant height of the inoculated control was 24.35 cm, which was the lowest plant height and significantly differed from the plant heights resulting from the other treatments. It was clearly demonstrated that treatment with all the biological fungicides tested also resulted in significantly different plant heights at 90 days after treatment, when compared with the plant height resulting from treatment with the chemical fungicide (P = 0.05). Bio-CG promoted plant growth significantly differently, and the resulting plant height was 60.52 cm. For treatment with Bio-CLT and Bio-T, the resulting plant heights were 51.55 and 49.20 cm, respectively. For the plants treated with difenoconazole and the untreated control, there was no significant difference in the plant heights, which were 45.60 and 44.93 cm, respectively, whereas the plant height of the inoculated control was 35.65 cm, which was the lowest plant height and significantly differed from the plant heights resulting from the other treatments (Table 6.6).
The results showed that for treatment with all the biological fungicides tested, the root length was significantly different when compared with the root length resulting from treatment with the chemical fungicide (P = 0.05). Bio-CG promoted plant growth significantly differently, and the resulting root length was 37.55 cm. For treatment with Bio-CLT and Bio-T, the resulting root lengths were 32.73 and 31.48 cm, respectively. For the plants treated with difenoconazole and the untreated control, there was no significant difference in the root lengths, which were 29.18 and 30.53 cm, respectively, whereas the root length of the inoculated control was 23.60 cm, which was the shortest root length and significantly differed from the root lengths resulting from the other treatments (Fig. 6.14). For all the biological fungicides tested, the plant fresh and dry weights were significantly different when compared with those of the inoculated control (P = 0.05). Treatment with Bio-CG resulted in a significantly different plant fresh weight of 51.55 g, whereas for treatment with Bio-CLT and Bio-T, the plant fresh weights were 43.61 and 41.75 g, respectively. For the plants treated with difenoconazole and the untreated control, the plant fresh weights were 33.43 and 34.92 g, respectively, and were not significantly different, whereas the plant fresh weight of the inoculated control was 22.63 g, which was the lowest plant fresh weight and significantly differed from the plant fresh weights resulting from the other treatments. Similarly, the plant dry weight after treatment with Bio-CG was 16.79 g, which significantly differed from the plant dry weights after the other treatments. For treatment with Bio-CLT and Bio-T, the plant dry weights were 14.44 and 12.40 g, respectively. For the plants treated with difenoconazole and the untreated control, there was no significant difference in the plant dry weights, which were 11.82 and 10.20 g, respectively, whereas the plant dry weight of the inoculated control was 6.49 g, which was the lowest plant dry weight and significantly differed from the plant dry weights resulting from the other treatments. For treatment with all the biological fungicides tested, the plant dry weight was significantly different when compared with that of the inoculated control (P = 0.05). The root fresh weight after treatment with Bio-CG was 10.97 g, which was significantly different from that after the other treatments. For treatment with Bio-CLT and Bio-T, the root fresh weights were 9.08 and 7.94 g, respectively. For the plants treated with difenoconazole and the untreated control, there was no significant difference in the root fresh weights, which were 7.45 and 7.17 g, respectively. The lowest root fresh weight was obtained for the inoculated control, and was 6.44 g and significantly differed from the root fresh weights resulting from the other treatments. Likewise, the root dry weight after treatment with Bio-CG was 2.73 g, which was the highest and significantly differed from the root dry weights resulting from the other treatments. For the plants treated with Bio-CLT, Bio-T, and difenoconazole and the untreated control, the root dry weights were 2.43, 2.21, 1.98, and 1.91 g, respectively. The lowest root dry weight was obtained for the inoculated control; it was 6.44 g and significantly differed from the root dry weights resulting from the other treatments (Table 6.7).
In addition to reducing disease incidence, biological fungicides increase fruit yield and the overall quality of the fruits. For all the biological fungicides tested, the number of fruits per plant was significantly different when compared with the number of fruits per plant for the inoculated control (P = 0.05). Treatment with Bio-CG, Bio-CLT, and Bio-T resulted in the highest fruit numbers, which were 13.50, 11.95, and 11.95 fruits per plant, respectively. For the plants treated with difenoconazole and the untreated control, there was no significant difference in the fruit numbers, which were 11.45 and 11.38 fruits per plant, respectively, whereas for the inoculated control, there were 9.85 fruits per plant, which was the lowest fruit number and significantly differed from the fruit numbers resulting from the other treatments (Fig. 6.14). For treatment with all the biological fungicides, the overall quality of the fruit was significantly different when compared with the overall quality resulting from treatment with the chemical fungicide (P = 0.05). The fruit lengths after treatment with Bio-CG, Bio-CLT, and Bio-T were 10.89, 10.77 and 10.52 cm, respectively, which significantly differed from the fruit lengths resulting from the other treatments. For the plants treated with difenoconazole, the untreated control, and the inoculated control, there was no significant difference in the fruit lengths, which were 9.36, 8.92, and 8.72 cm, respectively. Similarly, treatment with Bio-CG, Bio-CLT, and Bio-T also resulted in fruit diameters significantly different from those resulting from the other treatments; they were 1.66, 1.64, and 1.64 cm, respectively. For the plants treated with difenoconazole and the untreated control, the fruit diameters were 1.48 and 1.40 cm, respectively. The smallest fruit diameter was obtained for the inoculated control, and was 1.36 cm and significantly differed from the fruit diameters resulting from the other treatments. Moreover, treatment with all the biological fungicides resulted in significantly different yields when compared with the yield for the inoculated control (P = 0.05). Treatment with Bio-CG gave the highest yield, which was 152.77 g per plant, and this significantly differed from the yields resulting from the other treatments. Treatment with Bio-CLT and Bio-T gave yields of 119.17 and 118.20 g per plant, respectively. For the plants treated with difenoconazole and the untreated control, there was no significant difference in the yields, which were 99.13 and 91.51 g per plant. The lowest yield was obtained for the inoculated control, which was 71.20 g per plant (Fig. 6.11). It is clearly demonstrated that Bio-CG treatment increased the yield by 52.54 % which was significantly higher than that obtained by difenoconazole treatment (P = 0.05). Treatment with Bio-CLT and Bio-T increased the yield by 39.65 and 38.95 %, respectively. Application of difenoconazole gave the lowest yield of 28.04 %. (Figs. 6.12, 6.13, and 6.14).
The stem of long cayenne pepper exhibited a reaction when inoculated with C. capsici and treated with chaetoglobosin C from C. globosum, chaetomanone A from C. lucknowense, and trichotoxin A50 from T. harzianum PC01 at different concentrations. The reactions resulted in the induction of immunity response against C. capsici by a necrosis being expressed in the upper part of the plant. The length of the necrosis was significantly different at 5, 10, and 20 days after treatment with the microbial elicitors. The inoculated plants treated with chaetoglobosin C at concentrations of 10, 50, and 100 μg/ml showed shorter necrosis than the inoculated plants treated with chaetomanone A and trichotoxin A50. The length of the necrosis at each concentration did not differ significantly. This suggested that long cayenne pepper has a mechanism for recognizing this pathogen for the defense response. This finding is supported by Egea et al. (1996a), who reported that the stems of three cultivars of C. annuum exhibited a classic hypersensitive reaction when inoculated with P. capsici, and found that a resistant cultivar developed a defense response that resulted in a rapid and lasting restriction of the pathogen. Qualitative analysis of capsidiol accumulation was detected by TLC in this study. The results showed that capsidiol had accumulated in chilli plants 5 and 10 days after treatment with microbial elicitors, whereas no capsidiol was detected in noninoculated plants and the untreated control. After 20 days, no capsidiol was detected in all treatments, a finding supported by the previously mentioned report. Egea et al. (1996b) stated that the maximum level of capsidiol detected was in the necrotic zone 6 days after inoculation, whereas after 9 days, capsidiol levels fell in all chilli cultivars. Moreover, no capsidiol was induced in the healthy control. Ahmed et al. (2000) also found a susceptible variety of chilli which was treated with T. harzianum and inoculated with P. capsici, which causes root rot in chilli, stimulated the production of capsidiol, the concentration of which was highest after 6 days and fell after 9 days. In this study, capsidiol accumulation was also detected in noninoculated plants treated with chaetoglobosin C, chaetomanone A, and trichotoxin A50 at concentrations of 10, 50, and 100 μg/ml. This suggests that capsidiol, a phytoalexin, is produced by chilli plants not only in response to interaction with the fungal pathogen but also following treatment with microbial elicitors, in the same way as in report by Back et al. (1998), which suggested that phytoalexins are produced by plants following treatment with many chemicals, irradiation by ultraviolet light, and exposure to the products of microbial metabolism. Hwang and Sung (1989) demonstrated that the chemical fungicide metalaxyl also induced capsidiol in the stem of chilli plants infected with P. capsici. Bhapdal and Paxton (1991) state that phytoalexin biosynthesis are induced by the fungal glucan Polytran in sweet pepper tissues.
It is clearly demonstrated that the microbial elicitors chaetoglobosin C, chaetomanone A, and trichotoxin A50 can induce immunity against chilli anthracnose in pot experiments. This experiment showed that the PDR of chaetoglobosin C was 55 %, which was the highest reduction. This demonstrates that chaetoglobosin C is potent in inducin immunity in chilli plants. Similarly, induced immunity in citrus seedlings was reported by Treetong et al. (2000), who stated that chaetoglobosin C could be the induced immunizing agent against Phytophthora root and stem rot of Shogun citrus seedlings that could reduce the pathogen inoculum and incidence of root and stem rot. Moreover, Soytong et al. (2005) also stated that chaetoglobosin C could inhibit the growth of Colletotrichum gloeosporioides stain WMF01, which causes grape anthracnose, with a median effective dose between 1 and 50 ppm. Likewise, this study showed that antagonistic fungi, C. globosum KMITL-N0802 and C. lucknowense CLT, significantly reduced disease incidence by 55 and 42.5 %. This demonstrates that Chaetomium spp. are potent in reducing chilli anthracnose. This finding is also similar to that of Shternshis et al. (2005), who suggested that the mycofungicide Ketomium, which was developed from Chaetomium species, shows promise as a new means of biological control of plant diseases in Siberian conditions such as raspberry spur blight, which is caused by Didymella applanata, and potato disease caused by Rhizoctonia solani. Moreover, Soytong et al. (2001) reported that biological control of plant disease has been successfully reported by using a new broad-spectrum biological fungicide from Chaetomium and this has successfully been applied to infested field soils and integrated with cultural control measures and organic amendments for the long-term protection against durian and black pepper disease caused by Phytophthora palmivora, tangerine disease caused by Phytophthora parasitica, strawberry disease caused by Phytophthora cactorum, wilt of tomato caused by Fusarium oxysporum f. sp. lycopersici, and basal rot of corn caused by Sclerotium rolfsii. In this study, T. harzianum PC01 and trichotoxin A50 reduced disease by 38.75 and 42.5 %, respectively, whereas difenoconazole reduced disease by only 32.5 %. This demonstrates the potency of Trichoderma spp. and the active substance trichotoxin A50. A similar result was reported by Jebessa and Ranamukhaarachchi (2006), who stated that T. harzianum collected in the same regions as the chilli samples had some effect in controlling C. gloeosporioides, which causes chilli anthracnose in southern, central, and western chilli-growing regions of Ethiopia. In addition, Soytong et al. (2005) reported that crude extracts from T. harzianum PC01, T. harzianum PC02, and its antibiotic substance, namely, trichotoxin A50, could inhibit the growth of C. gloeosporioides strain WMF01, which causes grape anthracnose, with median effective doses between 1 and 50 ppm, and bioproducts of Trichoderma significantly reduced the incidence of disease on leaves, twigs, and fruits of grape as compared with the chemical control. Moreover, there is a report indicating that trichotoxin A50 from T. harzianum PC01 has significant immunizing ability against Phytophthora root rot of citrus seedling when compared with the chemical fungicide metalaxyl (Treetong et al. 2000). In this experiment, all the microbial elicitors and antagonistic fungi as biological fungicides were significantly different in their effectiveness in disease reduction when compared with a chemical fungicide (difenoconazole). This finding is also similar to that of Sariah (1989), who suggested that using a chemical fungicide resulted in little or no control of anthracnose in some major chilli-growing areas of Selangor, Malaysia. However, Gopinath et al. (2006) studied the efficacy of the chemical fungicide difenoconazole for chilli anthracnose management through extensive greenhouse and field trials and found that application of difenoconazole at 0.05 % reduced disease incidence by 58 %, whereas this study showed that difenoconazole reduced disease incidence by 32.5 %. The use of antagonistic fungi as biological fungicides and microbial elicitors from these antagonistic fungi not only reduced disease incidence but also increased the yield. This may be interpreted as being due to some antagonistic fungi not only controlling disease but also promoting growth (Jebessa and Ranamukhaarachchi 2006).
2 Microbial Elicitors Inducing Plant Disease Immunity in Tomato
The α-tomatine quantification of the extracts was performed by using high-performance liquid chromatography (HPLC) with a modified method of Friedman et al. (1994). The crude extracts (1 mg) from the tested plants were dissolved in 1 ml of mixed solvent comprising 50 % methanol and 0.1 % acetic acid and were filtered through a0.45-μm nylon membrane. The filtrate (50 μl) was subjected to HPLC (instrument from Agilent). The HPLC eluent for α-tomatine analysis was a combined solvent system comprising 80 % water, 15 % acetonitrile, and 5 % methanol (all HPLC grade). The flow rate was set to 1.0 ml/min. The C8 chromatography column was eluted with the HPLC solvent system before injection of the filtrates. The α-tomatine quantification was performed using a linear regression curve. Data were statistically analyzed by analysis of variance. Treatment means were compared by Duncan’s multiple range test at P = 0.05 and P = 0.01.
The experiment was performed to detect α-tomatine in the laboratory. The trial was conducted with the modified method of Melton et al. (1998) and designed in a completely randomized design with six treatments and three replications. Twenty-day-old seedlings of variety Sida were inoculated with a conidial suspension of F. oxysporum f. sp. lycopersici at a concentration of 2 × 106 conidia per milliliter and planted in 4-in.-diameter plastic pots containing a sterilized soil mixture as in the previous experiments, followed by spraying each bioactive compound or chemical fungicide on seedling leaves. The treatments were as follows: in treatment 1, the seedling was inoculated with the pathogen and sprayed with chaetoglobosin C at 50 μg/ml; in treatment 2, the seedling was inoculated with the pathogen and sprayed with chaetomanone A at 50 μg/ml; in treatment 3, the seedling was inoculated with the pathogen and sprayed with trichotoxin A50 at 50 μg/ml; in treatment 4, the seedling was inoculated with the pathogen and sprayed with prochloraz at 20 g/20 l water; in treatment 5, the seedling was inoculated with the pathogen. A noninoculated control was also studied. The disease severity scale of Silva and Bettiol (2005) as follows:- 1= no symptom; 2= plant showed yellowing leaves and wilting 1-20%, 3= plant showed yellowing leaves and wilting 21-40%, 4= plant showed yellowing leaves and wilting 41-60%, 5= plant showed yellowing leaves and wilting 61-80%, and 6= plant showed yellowing leaves and wilting or die 81-100%. The percentage of plant disease immunity (PDI) of the treated tomato seedlings was calculated using the following formula: PDI = DSI of inoculated control – DSI of each treatment/DSI of inoculated control × 100. The α-tomatine was extracted from 6 g of stems and leaves of tomato plants which were harvested at 5, 10, and 15 days after treatment. Then, plant tissues were ground in 95 % methanol with a mortar and pestle. The extracts was evaporated in a vacuum evaporator, and the volume was adjusted with methanol, and then they were subjected to TLC with standard α-tomatine for comparison. The spot of the extracts from the tested tomato which showed Rf = 0.23 was expected to be α-tomatine in each treatment.
The phytoanticipin α-tomatine was induced by the bioactive compounds chaetoglobosin C, chaetomanone A, and trichotoxin A50. The DSI was determined before the seedlings were harvested and analyzed for PDI. The PDI of tomato seedlings treated with chaetoglobosin C, chaetomanone A, and trichotoxin A50 after 10 days was 44.97, 35.18, and 39.43 %, respectively, whereas tomato seedlings treated with prochloraz showed PDI of 29.95 %. The extracts from tested tomato were spotted on TLC paper with standard α-tomatine for comparison. The spots of extracts on TLC paper were green in all treatments with Rf = 0.23, the as same for standard α-tomatine (Fig. 6.15). The quantity of α-tomatine at 5 days was analyzed, and the data revealed that inoculated seedlings treated with chaetoglobosin C contained the highest quantity of α-tomatine (746.67 μg/g sample), whereas inoculated seedlings treated with chaetomanone A and trichotoxin A50 contained significantly lower quantities of α-tomatine (535.01 and 599.79 μg/g sample, respectively). For inoculated seedlings treated with prochloraz, tomato seedlings inoculated with the pathogen only, and the noninoculated control, there was no significant difference in the quantity of α-tomatine—368.68, 361.51, and 294.38 μg/g sample, respectively. The seedlings treated with trichotoxin A50 contained 492.22 μg of α-tomatine per gram of sample, which was significantly higher than for seedlings treated with chaetoglobosin C and chaetomanone A and for the noninoculated control, which contained 348.72, 322.98, and 321.19 μg of α-tomatine per gram of sample after 10 days (Table 6.8). In addition, inoculated seedlings treated with prochloraz and tomato seedlings inoculated with the pathogen contained the lowest quantities of α-tomatine—190.82 and 179.87 μg/g sample. The quantity of α-tomatine was lower for all treatments at 15 days, except for the noninoculated control, which contained 365.91 μg of α-tomatine per gram of sample. The quantities of α-tomatine for seedlings treated with chaetoglobosin C, chaetomanone A, and trichotoxin A50 were not significantly different (207.87, 254.25, and 205.04 μg/g sample, respectively), whereas for seedlings treated with prochloraz and the inoculated control, the quantities were 131.56 and 77.46 μg/g sample, respectively.
Detection of α-tomatine 5, 10, and 15 days. after inoculation with Fusarium oxysporum f. sp. lycopersici and treatment with bioactive compounds. T1 treatment with chaetoglobosin C, T2 treatment with chaetomanone A, T3 treatment with trichotoxin A50, T4 treatment with prochloraz, T5 inoculation with the pathogen only, T6 noninoculated control. For thin-layer chromatography, S standard α- tomatine, 1 treatment with chaetoglobosin C, 2 treatment with chaetomanone A, 3 treatment with trichotoxin A50, 4 treatment with prochloraz, 5 inoculated control, 6 noninoculated control
In line with these findings, Soytong et al. (2001), Kanokmedhakul et al. (1993) mentioned that chaetoglobosin C extracted from C. globosum acts as an inducer of PDI for disease resistance by inducing a localized and subsystemic oxidative burst in tomato, tobacco, potato, and carrot. This ability of chaetoglobosin C is also supported by the work of Soytong et al. (2005). Chaetoglobosin C, chaetomanone A, and trichotoxin A50 exhibited strong inhibitory activity in vivo against tomato fusarium wilt. Inoculated tomato plants to which bioactive compounds were applied at 10–100 μg/ml showed higher PDI (53.80–65.15 %) than those to which prochloraz was applied (26.73 %). This result is supported by reports of Soytong et al. (2001) and Suwan et al. (2000), who stated that chaetoglobosin C and trichotoxin A50 can elicit resistance or immunity in tomato and other plants, inhibit the pathogen, and stimulate plant growth. From the results, tomato plants treated with bioactive compounds showed significant differences in plant height, plant fresh weight, and plant dry weight in comparison with tomato plants tread with prochoraz and the inoculated control. This finding is similar to that of Soytong et al. (2007), who reported that trichotoxin A50 exhibited potential as a plant growth regulator in Chinese cabbage, kale, and mungbean. Moreover, Phuwiwat and Soytong (1999) stated that the same strain of T. harzianum PC01 could also promote the growth of Chinese radish and improve yield.
3 Concluding Remarks
Long cayenne pepper clearly has a mechanism for recognizing the fungal pathogen C. capsici C208 for the defense response by necrosis when inoculated with C. capsici and treated with chaetoglobosin C, chaetomanone A, and trichotoxin A50 at different concentrations. Qualitative capsidiol accumulation was found in chilli plants at 5 and 10 days after treatment with all three microbial elicitors at all concentrations, whereas no capsidiol was detected in the noninoculated and untreated control. Moreover, capsidiol was not detected in plants subjected to all treatments after 20 days.
The long cayenne pepper production in pot experiments using microbial elicitors, that is, chaetoglobosin C, chaetomanone A, and trichotoxin A50, and using biological fungicides as Bio-CG (C. globosum KMITL-N0802), Bio-CLT (C. lucknowense CLT), and Bio-T (T. harzianum PC01) compared with a chemical fungicide (difenoconazole) clearly demonstrated that these microbial elicitors and biological fungicides can reduce disease incidence. Chaetoglobosin C, chaetomanone A, and trichotoxin A50 significantly reduced disease incidence by 55.0, 50.0, and 42.5 %, respectively, when compared with difenoconazole, which reduced disease incidence by only 32.5 %. Additionally, treatment with chaetoglobosin C, chaetomanone A, and trichotoxin A50 significantly increased the yield by 55.17, 48.49, and 46.53 %, respectively, when compared with treatment with difenoconazole, which increased the yield by 25.31 %. Likewise, treatment with Bio-CG, Bio-CLT, and Bio-T significantly reduced disease incidence by 55.0, 42.5, and 38.75 %, respectively, when compared with treatment with difenoconazole, which reduced disease incidence by only 32.5 %. Finally, treatment with Bio-CG, Bio-CLT, and Bio-T also significantly increased the yield by 52.54, 39.65, and 38.95 %, respectively, when compared with treatment with difenoconazole, which increased the yield by 28.04 %. These results suggest a new means of inducing immunity against chilli anthracnose in chilli production. Moreover, it was clearly shown that these antagonistic fungi and their active substances not only control disease but also promote the growth of chilli.
Chaetoglobosin C, chaetomanone A, and trichotoxin A50 also acted as microbial elicitors to induce immunity in tomato plant variety Sida by eliciting α-tomatine. Tomato plants treated with the bioactive compounds had PDI between 35.18 and 44.97 %. The bioactive compounds elicit α-tomatine between 205.04 and 254.25 μg/g, which is higher than the concentration elicited by the chemical fungicide (prochloraz) and in the inoculated control (131.56 and 77.46 μg/g) at 15 days after treatment with the pathogen. Further, the bioactive compounds were tested for their abilities as microbial elicitors to induce PDI to control tomato wilt in vivo. Chaetoglobosin C, chaetomanone A, and trichotoxin A50 at concentrations of 10, 50 and 100 μg/ml induced immunity in tomato plants with PDI between 53.80 and 65.15 %, which is higher than that for prochloraz, which resulted in PDI of only 26.73 %.
References
Ahmed AS, Sánchez CP, Candela ME (2000) Evaluation of induction of systemic resistance in pepper plants (Capsicum annuum) to Phytophthora capsici using Trichoderma harzianum and its relation with capsidiol accumulation. Eur J Plant Pathol 106(9):817–824
Back K, He S, Kim KU, Shin DH (1998) Cloning and bacterial expression of sesquiterpene cyclase, a key branch point enzyme for the synthesis of sesquiterpenoid phytoalexin capsidiol in UV-challenged leaves of Capsicum annuum. Plant Cell Physiol 39(9):899–904
Bhandal IS, Paxton JD (1991) Phytoalexin biosynthesis induced by the fungal glucan Polytran L in soybean, pea, and sweet pepper tissues. J Agric Food Chem 39(12):2156–2157
Chávez-Moctezuma MP, Lozoya-Gloria E (1996) Biosynthesis of the sesquiterpenic phytoalexin capsidiol in elicited root cultures of chilli pepper (Capsicum annuum). Plant Cell Rep 15(5):360–366
Egea C, Alcázar MD, Candela ME (1996a) Capsidiol: its role in the resistance of Capsicum annuum to Phytophthora capsici. Physiol Plant 98(4):737–742
Egea C, García-Pérez MD, Candela ME (1996b) Capsidiol accumulation in Capsicum annuum stems during the hypersensitive reaction to Phytophthora capsici. J Plant Physiol 149(6):762–764
Friedman M, Levin CE, McDonald GM (1994) α-Tomatine determination in tomatoes by HPLC using pulsed amperometric detection. J Agric Food Chem 42(9):1959–1964
García-Pérez MD, Egea C, Candela ME (1998) Defence response of pepper (Capsicum annuum) suspension cells to Phytophthora capsici. Physiol Plant 103(4):527–533
Gopinath K, Radhakrishnan NV, Jayaraj J (2006) Effect of propiconazole and difenoconazole on the control of anthracnose of chilli fruits caused by Colletotrichum capsici. Crop Prot 25(9):1024–1031
Hammerschmidt R (1999) Phytoalexins: what have we learned after 60 years? Annu Rev Phytopathol 37(1):285–306
Hoshino T, Yamaura T, Imaishi H, Chida M, Yoshizawa Y, Higashi K, Ohkawa H, Mizutani J (1995) 5-epi-Aristolochene 3-hydroxylase from green pepper. Phytochemistry 38(3):609–613
Hwang BK, Sung NK (1989) Effect of metalaxyl on capsidiol production in stems of pepper plants infected with Phytophthora capsici. Plant Dis 73(9):748–751
Jebessa MT, Ranamukhaarachchi SL (2006) Attempts to biologically control anthracnose disease in chilli peppers. Trop Sci 46(2):74–77
Kanokmedhakul K, Kanokmedhakul S, Soytong K (1993) Testing of chaetomium and some plant extracts for controlling fusarium wilt of tomato (Fusarium oxysporum f. sp. lycopersici). J Agric Res Ext 10:5–9
Kanokmedhakul S, Kanokmedhakul K, Phonkerd N, Soytong K, Kongsaeree P, Suksamrarn A (2002) Antimycobacterial anthraquinone-chromanone compound and diketopiperazine alkaloid from the fungus Chaetomium globosum KMITL-N0802. Planta Med 68:834–836
Kanokmedhakul S, Kanokmedhakul K, Nasomjai P, Louangsysouphanh S, Soytong K, Isobe M, Kongsaeree P, Prabpai S, Suksamrarn A (2006) Antifungal azaphilones from the fungus Chaetomium cupreum CC3003. J Nat Prod 69 (23):891–895
Ma CJ (2008) Cellulase elicitor induced accumulation of capsidiol in Capsicum annuum L. suspension cultures. Biotechnol Lett 30(5):961–965
Melton RE, Flegg Brown LM, James KM, Oliver RP, Daniels MJ, Osbourn AE (1998) Heterologous expression of Septoria lycopersici tomatinase in Cladosporium fulvum: effects on compatible and incompatible interactions with tomato seedlings. Mol Plant Microbe Interact 11(3):228–236
Phuwiwat W, Soytong K (1999) Growth and yield response of Chinese radish to application of Trichoderma harzianum. Thammasat Int J Sci Technol 4:68–71
Sariah M (1989) Detection of benomyl resistance in the anthracnose pathogen, Colletotrichum capsici. J Islamic Acad Sci 2(3):168–171
Shternshis M, Tomilova O, Shpatova T, Soytong K (2005) Evaluation of Ketomium-mycofungicide on Siberian isolates of phytopathogenic fungi. J Agric Technol 1(2):247–253
Soytong K, Kanokmedhakul S, Kukongviriyapa V, Isobe M (2001) Application of Chaetomium species (Ketomium®) as a new broad spectrum biological fungicide for plant disease control: a review article. Fungal Divers 7:1–15
Soytong K, Srinon W, Ratanacherdchai K, Kanokmedhakul S, Kanokmedhakul K (2005) Application of antagonistic fungi to control anthracnose disease of grape. J Agric Technol 1(1):33–41
Soytong K, Kanokmedhakul S, Kanokmedhakul K, Suksamrarn A (2007) Bioactive compounds from Chaetomium cupreum, C. globosum and Trichoderma harzianum for plant disease control and plant growth stimulant. Proceedings of the International conference on engineering, applied sciences and technology, 21–23 November 2007, Bangkok, Thailand, p 46
Suwan S, Isobe M, Kanokmedhakul S, Lourit N, Kanokmedhakul K, Soytong K, Koga K (2000) Elucidation of high micro-heterogeneity of an acidic-neutral trichotoxin mixture from Trichoderma harzianum by electrospray ionization quadrupole time-of-flight mass spectrometry. J Mass Spectrom 35(12):1438–1451
Treetong W, Soytong K, Kanokmedhakul S (2000) Integrated biological control of Shogun orange (Citrus reticulata Blanco cv. Shogun) root and stem rot. J Agric Res Ext 17(2):31–42
Walters D, Walsh D, Newton A, Lyon G (2005) Induced resistance for plant disease control: maximizing the efficacy of resistance elicitors. Phytopathology 95(12):1368–1373
Watson DG, Brooks CJW (1984) Formation of capsidiol in Capsicum annuum fruits in response to non-specific elicitors. Physiol Plant Pathol 24(3):331–337
Zavala-Páramo G, Chávez-Moctezuma MP, García-Pineda E, Yin S, Chappell J, Lozoya-Gloria E (2000) Isolation of an elicitor-stimulated 5-epi-aristolochene synthase gene (gPEAS1) from chilli pepper (Capsicum annuum). Physiol Plant 110(3):410–418
Zbell B, Walter-Back C (1989) Signal transduction of auxin on isolated plant cell membrane: indications for a rapid polyphosphoinositide response stimulate by indoleacetic acid. J Plant Physiol 133:353–360
Zook M, Hohn T, Bonnen A, Tsuji J, Hammerschmidt R (1996) Characterization of novel sesquiterpenoid biosynthesis in tobacco expressing a fungal sesquiterpene synthase. Plant Physiol 112(1):311–318
Author information
Authors and Affiliations
Corresponding author
Editor information
Editors and Affiliations
Rights and permissions
Copyright information
© 2014 Springer India
About this chapter
Cite this chapter
Soytong, K., Kanokmedhakul, S., Rattanacherdchai, K., Charoenporn, C. (2014). Microbial Elicitors to Induce Immunity for Plant Disease Control in Chilli and Tomato. In: Sahayaraj, K. (eds) Basic and Applied Aspects of Biopesticides. Springer, New Delhi. https://doi.org/10.1007/978-81-322-1877-7_6
Download citation
DOI: https://doi.org/10.1007/978-81-322-1877-7_6
Published:
Publisher Name: Springer, New Delhi
Print ISBN: 978-81-322-1876-0
Online ISBN: 978-81-322-1877-7
eBook Packages: Biomedical and Life SciencesBiomedical and Life Sciences (R0)